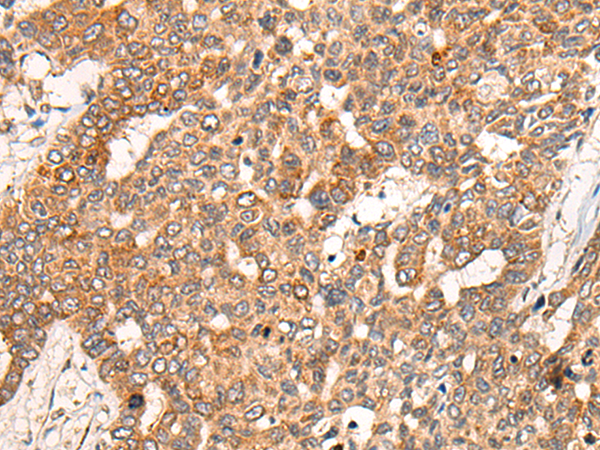
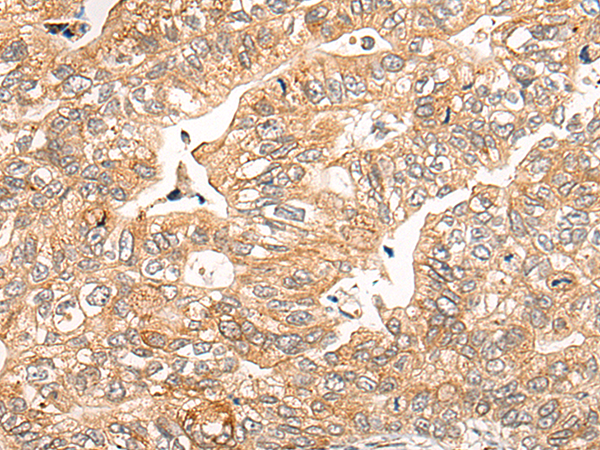
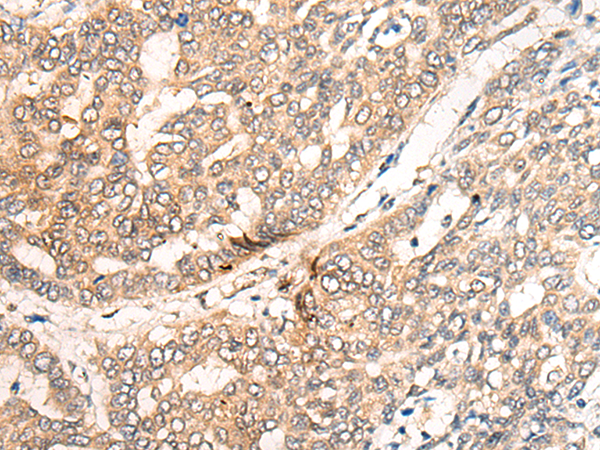

-
分类: 科研抗体货号: P09472别名:应用: IHC反应种属: Human, Mouse, Rat
-
分类: 科研抗体货号: P09492别名: CGR11应用: IHC反应种属: Human
-
分类: 科研抗体货号: P09471别名:应用: IHC反应种属: Human, Mouse
-
分类: 科研抗体货号: P09491别名: CFP1; CGBP; SPP1; PCCX1; PHF18; hCGBP; ZCGPC1; HsT2645; 2410002I16Rik; 5830420C16Rik应用: IHC反应种属: Human, Mouse
-
分类: 科研抗体货号: P09470别名: DOC1; ST19; DORC1; doc-1; p12DOC-1应用: IHC反应种属: Human, Mouse
-
分类: 科研抗体货号: P09488别名: CESK1应用: IHC反应种属: Human
-
分类: 科研抗体货号: P09469别名: p14; DOC-1R应用: IHC反应种属: Human, Mouse
-
分类: 科研抗体货号: P09487别名: CERD4; BAF45C应用: IHC反应种属: Human
-
分类: 科研抗体货号: P09468别名: CDH7; CDH7L2应用: IHC反应种属: Human
-
分类: 科研抗体货号: P09486别名: DAND4应用: IHC反应种属: Human

鄂公网安备42018502007531号
鄂公网安备42018502007531号

